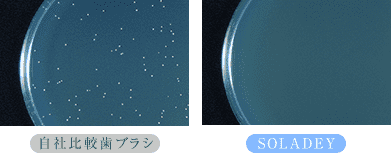
細菌の増殖を抑制実験写真

効果
きれいを、実感しつづける。
きれいに磨ける。きれいがつづく。
効果を追求することで、SOLADEY3は生まれました。
-
1こびりついた歯垢をブラッシング&化学的に除去

4週間自社比較歯ブラシとソラデーを使用後の比較。
口腔内の歯垢量を調査した結果、
自社比較歯ブラシではほぼ変化がなく、
ソラデーでは歯垢が42.7%減少していることが確認されています。歯垢除去効果検討臨床実験
大阪大学歯学部附属病院障害者歯科治療部調べ -
2歯のエナメル質を溶かす乳酸を分解

歯垢は口の中にある糖分を栄養源に、歯を溶かす乳酸をつくります。
ソラデーはこの乳酸を経時的に分解します。乳酸溶液pH変化実験 ㈱住化分析センター調べ
-
3細菌の増殖を抑制
自社比較歯ブラシとソラデーを細菌培養液に3分間浸した後、寒天培地で48時間培養。
ソラデーは細菌の増殖を抑制しています。殺菌効果試験(一財)日本食品分析センター調べ


























